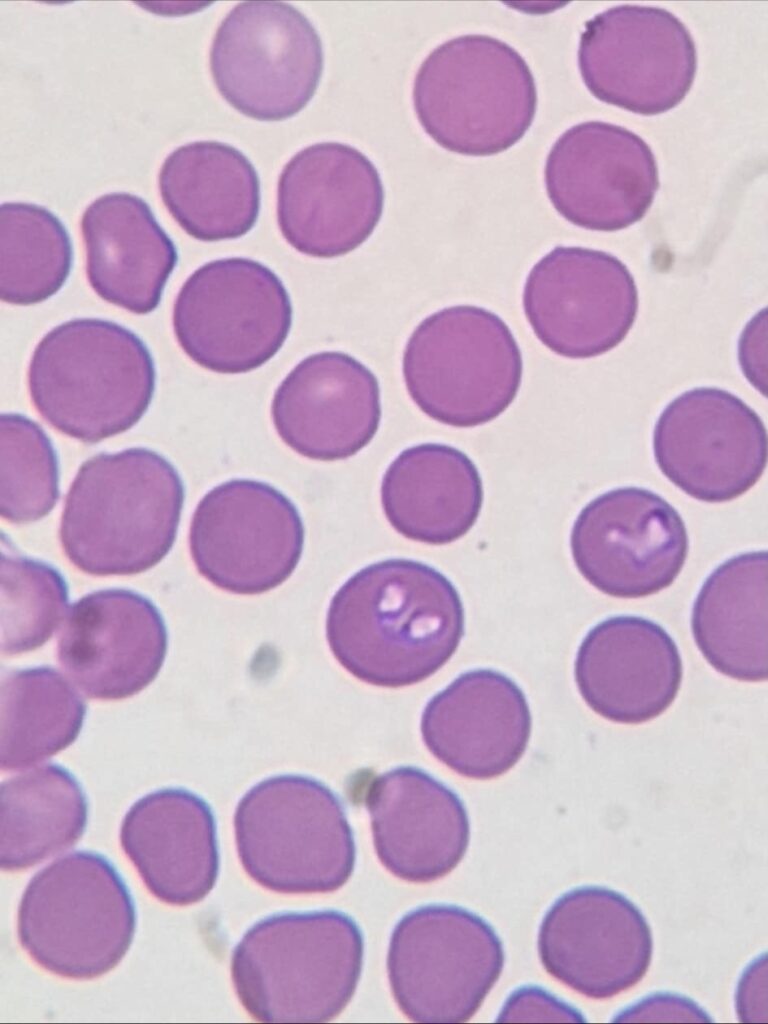

Kým väčšina z nás má pocit, že s prvými mrazmi sa nebezpečenstvo kliešťov končí, žilinská veterinárna klinika upozorňuje na pravý opak. Nedávny prípad desaťročného Kirana je jasným dôkazom, že ochrana proti parazitom je dôležitá aj v období, keď by sme ich výskyt čakali najmenej.
Kiran prišiel na kliniku so silnými horúčkami a výraznou stratou chuti do jedla. Jeho majiteľke bolo hneď jasné, že niečo nie je v poriadku. Zdravotný stav sa rýchlo zhoršoval a potreboval okamžitú odbornú pomoc.

MVDr. Kostrová začala stabilizáciou – postupne znižovala Kiranu teplotu infúznou terapiou, chladením aj liekmi s antipyretickým účinkom. Paralelne prebiehali krvné testy, ktoré ukázali prítomnosť silnej infekcie, no bez typických zmien, ktoré by hneď ukázali na pôvodcu.
Rozhodujúci zlom prinieslo až vyhodnotenie krvného náteru. Diagnóza bola neúprosná – babezióza, ochorenie spôsobené parazitmi prenášanými kliešťami. Tie napádajú červené krvinky, čo môže veľmi rýchlo ohroziť život psa.
Po stanovení diagnózy veterinárka okamžite nasadila cielenú terapiu. Kiran sa ukázal ako veľký bojovník – deň po dni sa mu vracali sily aj chuť do života. Dnes je už v plnej kondícii a čaká ho len kontrolné vyšetrenie a opakované podanie liečby.
Prípad Kirana je silným pripomenutím, že kliešte sú aktívne aj mimo sezóny a riziko infekcie nikdy neklesá na nulu. Veterinári preto odporúčajú nepoľavovať v prevencii ani počas chladných mesiacov.
Pre mnohých majiteľov je to možno prekvapenie, no práve takéto príbehy dokazujú, že pár minút mesačne venovaných ochrane môže rozhodnúť o zdraví – a niekedy aj o živote ich štvornohého parťáka.










